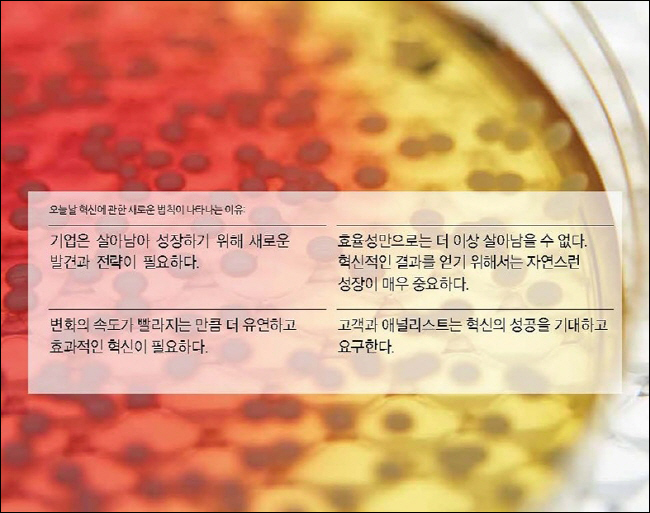

¼º°ø ±â¾÷À» À§ÇÑ Çõ½ÅÀÇ ¸ðµç °Í
¾î¶»°Ô »ì¾Æ³²À» °ÍÀΰ¡
ÀÌ Ã¥Àº ¹Ì±¹ÀÇ ´Ù±¹Àû ÄÁ¼³ÆÃ ȸ»ç°¡ 30³â µ¿¾È ºñÁî´Ï½º ÇöÀå¿¡¼ °æÇèÇÑ ¼º°ø°ú ½ÇÆÐ»ç·Ê¸¦ ¿¬±¸ÇÏ°í ºÐ¼®ÇÏ¿©, Çõ½Å¿¡ ¼º°øÇÑ ºñÁî´Ï½º ¸ðµ¨Àº ÀÏÁ¤ÇÑ ÆÐÅϰú ±ÔÄ¢ÀÌ Á¸ÀçÇÑ´Ù´Â »ç½ÇÀ» ÆÄ¾ÇÇϰí, ÀڽŵéÀÇ °æÇèÀ» Åä´ë·Î 10°¡Áö Çõ½Å À¯ÇüÀ» ü°èÀûÀ¸·Î Á¤¸®ÇÑ °ÍÀÌ´Ù.
10°¡Áö Çõ½Å À¯ÇüÀ» ÀûÀýÈ÷ Á¶ÇÕÇÏ¸é °ÔÀÓÀÇ ÆÇµµ¸¦ ¹Ù²Ù´Â Çõ½ÅÀ» ÀÌ·ê ¼ö ÀÖ´Ù. ÀÌ 10°¡Áö À¯ÇüÀÇ È°¿ë¹æ¹ýÀº Ã¥À» ¸ôÀÔÇØ¼ ÀÐ´Â´Ù¸é ½±°Ô ÆÄ¾ÇÇÒ ¼ö ÀÖÀ» °ÍÀÌ´Ù. ±×·¯³ª ¸í½ÉÇØ¾ß ÇÒ °ÍÀº À̰ÍÀÌ ´Ü¼øÇÑ ¹ß°ßÀÌ ¾Æ´Ï¶ó´Â Á¡ÀÌ´Ù. ÀÌ Ã¥Àº Çõ½Å ÇÁ·¹ÀÓ¿öÅ©¿Í ÇÔ²² Ä¡¹ÐÇÑ °èȹ°ú ÇÁ·Î¼¼½º¸¦ Ȱ¿ëÇÏ¿© Çõ½ÅÀ» ½ÇÇöÇÏ´Â ¹æ¹ý±îÁö ±¸Ã¼ÀûÀ¸·Î Á¦½ÃÇϰí ÀÖ´Ù.
Çõ½ÅÀÇ ¼º°ø ¿©ºÎ°¡ Ź¿ùÇÑ Àç´ÉÀ» °¡Áø °³Àο¡°Ô ´Þ·Á ÀÖ´Ù°í »ý°¢Çϱ⠽±´Ù. ÇÏÁö¸¸ Çõ½Å°¡ ÇÑ »ç¶÷¿¡°Ô ÀÇÁ¸ÇÏ´Â Á¶Á÷Àº ½ÇÆÐÇÒ ¼ö¹Û¿¡ ¾ø´Ù. ¿¬±¸ °á°ú¿¡ µû¸£¸é, È¿°úÀûÀÎ Çõ½Å ¹æ¹ýÀ» »ç¿ëÇϵµ·Ï ±³À°¹ÞÀº ÆÀÀÌ Àü¼¼°è Æò±Õ¿¡ ºñÇØ ¾à 10~20¹è ´õ ÁÁÀº °á°ú¸¦ ³º¾Ò´Ù. Çõ½ÅÀº ¡®´Üü½ºÆ÷Ã÷¡¯¶ó°í ÇÒ ¼ö ÀÖ´Ù. ±×·¸±â ¶§¹®¿¡ ¼Ò¼öÀÇ ÃµÀ糪 Ź¿ùÇÑ Àç´ÉÀ» °¡Áø »ç¶÷¸¸ Çõ½ÅÇÒ ¼ö ÀÖ´Â °ÍÀÌ ¾Æ´Ï¶ó ´©±¸µçÁö ¹è¿ì°í ³ë·ÂÇÑ´Ù¸é ¼º°øÀûÀ¸·Î Çõ½ÅÇÒ ¼ö ÀÖ´Ù.
ÀÌ Ã¥¿¡¼ ÁÖÀåÇÏ´Â °ÍÀº ¹Ù·Î ¡®¾î¶»°Ô Çõ½ÅÀ» È¿°úÀûÀ¸·Î ÇÒ ¼ö ÀÖÀ»±î¡¯ÀÌ´Ù. ´ç¸éÇÑ °úÁ¦°¡ Å©µç ÀÛµç, ´Ü±â°£¿¡ ÇØ°áÇÒ ¼ö ÀÖµç ¿À·¡ °É¸®µç »ó°ü¾øÀÌ ¹Ì·¡°¡ ºÒÈ®½ÇÇÒ ¶§ ¾î¶»°Ô ¸ñÇ¥¿¡ µµ´ÞÇÒ ¼ö ÀÖ´ÂÁö ȤÀº ¸¶Áö¸· ±âȸ¸¸ ³²Àº ÆÀ¿¡°Ô ¾î¶»°Ô ¼º°øÇÒ ¼ö Àִ°¡¿¡ ´ëÇÑ ÇØ°áÃ¥À» Á¦°øÇÏ´Â °ÍÀÌ ÀÌ Ã¥ÀÇ ¸ñÇ¥ÀÌ´Ù.
ȹ±âÀû Çõ½ÅÀº ¶Ù¾î³ Áö½Ä¿¡ ±â¹ÝÇÑ´Ù. ¾î·Á¿î ¹®Á¦¸¦ Ç® ¼ö ÀÖ´Â ´õ ³ªÀº Çõ½Å ¹æ¹ýÀÌ ÀÖÁö¸¸, ´ëºÎºÐÀÇ ±â¾÷Àº ¾ÆÁ÷µµ ½Ã´ë¿¡ µÚÃÄÁø °ú°ÅÀÇ ±â¼úÀ» »ç¿ëÇϰí ÀÖ´Ù. ÀÌ Ã¥Àº Çõ½ÅÀº Áö¼Ó°¡´ÉÇÑ °æ¿µ¿¡ ÀÖ¾î¼ Çʼö¶ó°í ÆÇ´ÜÇϰí Çõ½Å±³À°¿¡ ¿Á¤À» º¸ÀÌ´Â ¸®´õ, Çõ½Å¿¡µµ ´Ù¸¥ °æ¿µ °úÇÐó·³ ¾ö°ÝÇÑ ±âÁØÀÌ ÇÊ¿äÇÏ´Ù°í »ý°¢ÇÏ´Â »ç¶÷µéÀ» À§ÇÑ °ÍÀÌ´Ù.
¡ººñÁî´Ï½º ¸ðµ¨ÀÇ Çõ½Å¡»Àº ¸ðµç »ê¾÷ ºÐ¾ß¿¡ Àû¿ëÇÒ ¼ö ÀÖ´Â ·Îµå¸ÊÀ» Á¦°øÇÒ °ÍÀÌ´Ù.
¡°ºñÁî´Ï½º ¸ðµ¨ÀÇ Çõ½ÅÀº Çõ½ÅÀÇ Á¶Á÷¹®È¸¦ ±¸ÃàÇϱâ À§ÇØ ÁøÁöÇÏ°Ô °í¹ÎÇϰí ÀÖ´Â °æ¿µÀÚ¶ó¸é ¹Ì·¡ÀÇ ¿Ïº®ÇÑ °³³äÀ» ±â´Ù¸®±âº¸´Ù´Â Áö±Ý ¹Ýµå½Ã Àоî¾ß ÇÒ Ã¥ÀÌ´Ù.¡±
- ·ÎÀú L. ¸¶Æ¾, ÇÐÀå, ·ÎÆ®¸¸ °æ¿µ´ëÇÐ
¡°ÀÌ Ã¥Àº ºñÁî´Ï½ºÀÇ Çõ½ÅÀ» À§ÇÑ È°µ¿¿¡ ´ëÇØ ´Ù½Ã »ý°¢ÇϰԲû ÇÏ´Â ¶Ù¾î³ ÇÁ·¹ÀÓ¿öÅ©¸¦ Á¦°øÇÑ´Ù. ¶ÇÇÑ Çõ½Å¿¡ ´ëÇÑ °³³äÀ» ¸¶¼ú¿¡¼ ÁøÁ¤ÇÑ °úÇÐÀ¸·Î ²ø¾î¿Ã¸± °ÍÀÌ´Ù.¡±
- ¶öÇÁ Á¦·Ò, ºÎȸÀå, Coprporate Innovation, Mars, Inc.
¡°ºñÁî´Ï½º ¸ðµ¨ÀÇ Çõ½ÅÀº ¾î´À »ê¾÷ºÐ¾ß¿¡¼³ª Çõ½ÅÀûÀÎ º¯È¸¦ ÀÌ·ê ¼ö ÀÖ´Â ·Îµå¸ÊÀ» Á¦°øÇϸç, Çõ½Å¿¡ ¾ø¾î¼´Â ¾È µÉ ½Ç¿ë¼°¡ µÉ °ÍÀÌ´Ù.¡±
- ´ÏÄÝ¶ó½º F. ¶ó·ç¼Ò ¹Ú»ç, ¸ÞµðÄà °¨µ¶, ¸ÞÀÌ¿ä Ŭ¸®´Ð Çõ½Å¼¾ÅÍ
¡°ÀÌ Ã¥Àº »õ·Î¿î ¿µ¿ª¿¡ µµÀüÀåÀ» ³»¹Ì´Â âÁ¶ÀûÀÎ º¥Ã³ÆÀÀ» ¾È³»ÇÒ Á¾ÇÕÀûÀÎ Áöµµ¸¦ Á¦°øÇϸé¼, 30³â°£ÀÇ Çõ½Å ¿¬±¸ÀÇ °á°ú¹°·Î Ȱµ¿ÁöÇâÀûÀÎ ÇÁ·¹ÀÓ¿öÅ©¸¦ Á¦½ÃÇϰí ÀÖ´Ù.¡±
- µðÆÅ C. Á¦ÀÎ, ÇÐÀå, INSEAD
¡°ºñÁî´Ï½º ¸ðµ¨ÀÇ Çõ½ÅÀº Çõ½Å Ȱµ¿À» ½ÃÀÛÇÒ ¶§ ÇÊ¿äÇÑ ÅëÂû·ÂÀ» Á¦°øÇÑ´Ù.¡±
- ÄÃÆ® ³ë³ë¸¶Äû, ȸÀå, VHA

Çõ½ÅÀ» ÇØ¾ß ÇÏ´Â ¶§, À繫, ¸¶ÄÉÆÃ, À¯Åë µî °æ¿µÇÐÀ» °øºÎÇϰí ÀÌÇØÇÏ´Â ±â¾÷ ÀÓ¿øµéÁ¶Â÷ Çõ½Å¿¡ °üÇÑ Å͹«´Ï¾ø´Â ÀǰßÀ» ¼ö¿ëÇÏ´Â °æ¿ì°¡ ¸¹´Ù. ÈçÈ÷ »ç¶÷µéÀº Çõ½ÅÀ̶ó°í ÇÏ¸é ¾µµ¥¾ø´Â ¾ÆÀ̵ð¾î¸¸ ½ñ¾Æ³»´Â ºê·¹ÀνºÅä¹ÖÀ» Á¤¸®ÇÏ´Â Á¤µµ·Î »ý°¢ÇÑ´Ù. ȤÀº ¸»µµ ¾È µÇ´Â ¹ß»óÀÌ ±â¾÷ Àüü·Î È®»êµÇÁö ¸øÇϵµ·Ï ƯÁ¤ ¿¬±¸¼Ò³ª Àü´ãÁ¶Á÷À» ÅëÇØ Çõ½ÅÀ» ½ÃµµÇϱ⵵ ÇÑ´Ù. À̴ âÀǼºÀ» ³ôÀ̱⿡¸¸ ÀûÀýÇÒ »ÓÀÌ´Ù. -20ÂÊ
Çõ½ÅÀÇ 10°¡Áö À¯ÇüÀº ´Ü¼øÇϰí ÀÌÇØÇϱ⠽±´Ù. ÁøÇà ÁßÀÎ Çõ½ÅÀ» °ËÅäÇϰųª °¡Ä¡¸¦ ³ôÀ̱â À§ÇØ Çõ½ÅÀÇ 10°¡Áö À¯ÇüÀ» Ȱ¿ëÇÒ ¼öµµ ÀÖ´Ù. ¶ÇÇÑ °æÀïÀÚÀÇ »ç¾÷±¸Á¶¸¦ ºÐ¼®Çϱâ À§Çؼµµ À¯¿ëÇÏ°Ô »ç¿ëÇÑ´Ù. ƯÈ÷ Çõ½ÅÀÇ 10°¡Áö À¯ÇüÀ» ¸ð¸£¸é °£°úÇϱ⠽¬¿î ¿À·ù¸¦ ¹æÁöÇϰí Çõ½ÅÀÇ ¸ñÀûÀ» ºÐ¸íÈ÷ ÇÒ ¼ö ÀÖ´Ù´Â Ãø¸é¿¡¼µµ À¯¿ëÇÏ´Ù. -34ÂÊ
¹öÁøÀÇ ºñÁî´Ï½º Æ÷Æ®Æú¸®¿À´Â À̵¿ÀüÈ, ¿î¼Û, ±ÝÀ¶, ¹Ìµð¾î, ÇÇÆ®´Ï½º¸¦ Æ÷ÇÔÇÑ ¾ÆÁÖ ´Ù¾çÇÑ ºÐ¾ß¸¦ Æ÷°ýÇÑ´Ù. ÀϹÝÀûÀ¸·Î ±â¾÷ÀÇ ¸®´õ´Â Èûµé°í Áö·çÇÒÁö¶óµµ ¼º°øÀ» °ÅµÑ Áß¿äÇÑ »ç¾÷À» ã´Â´Ù. ÃÖ±Ù ¸î ³â µ¿¾È ¹öÁø ±×·ì ³»¿¡¼ ³ôÀº °ü½ÉÀ» ¹Þ°í ÀÖ´Â »ç¾÷ ºÐ¾ß´Â ¹öÁø °¶·¯Æ½(Virgin Galactic)À¸·Î, ¿ìÁÖ¿©ÇàÀ» »ó¾÷ÀûÀ¸·Î °¡´ÉÇÏ°Ô ÇÏ·Á´Â ºê·£½¼ÀÇ È¥½ÅÀÇ ³ë·ÂÀÌ ´ã°Ü ÀÖ´Ù. -70ÂÊ
1990³â 11¿ù, ³ªÀÌŰ´Â ³ªÀÌŰŸ¿î(Niketown)ÀÇ ÇüÅ·Πä³Î Çõ½ÅÀ» Ã˹߽ÃÄ×´Ù. ÀÌ Ç÷¡±×½Ê ½ºÅä¾î´Â ¡®°ø¿¬Àå °°Àº ¸ÅÀ塯 ¿ªÇÒÀ» Çß´Ù. »Ó¸¸ ¾Æ´Ï¶ó ³ªÀÌŰ¿¡°Ô À־ Á¦Ç°À» Àü½ÃÇÏ´Â °ø°£À̾úÀ¸¸ç, °í°´¿¡°Ô ³ªÀÌŰ´Â Æò¹üÇÑ ½Å¹ß ÆÇ¸Å±â¾÷ÀÌ ¾Æ´ÔÀ» ¾Ë¸®´Â ¹æ¹ýÀ̱⵵ Çß´Ù. ÀÌ´Â ÀÌÀü±îÁö´Â Á¦Ç°¿¡¸¸ ÃÊÁ¡À» ¸ÂÃèÁö¸¸ ÀÌÁ¦´Â ºê·£µå Çõ½ÅÀ¸·Î Áß½ÉÃàÀ» ÀüȯÇÑ´Ù´Â ½ÅÈ£À̱⵵ ÇÏ¿´´Ù. -142ÂÊ
ÇÒ¸®µ¥À̺ñ½¼Àº ¿Á¤ÀûÀÎ °í°´Ãþ¿¡°Ô Áö¼ÓÀûÀÎ ÁöÁö¸¦ ¹Þ°í ÀÖ´Ù. ¶ÇÇÑ ¡®Â÷°í ÆÄƼ¡¯ °°Àº Á¤±âÀûÀÎ ¸ðÀÓÀ̳ª ¼¼°è °¢Áö¿¡¼ ¿¸®´Â À̺¥Æ®¸¦ ÅëÇØ °í°´µé°ú ¿¬°á°í¸®¸¦ À¯ÁöÇÑ´Ù. ÀÌ »ó¡ÀûÀÎ ¸ðÅͽÎÀÌŬµéÀº ¿©¼º, û¼Ò³â ±×¸®°í È÷½ºÆÐ´Ð »çÀÌ¿¡¼ ÀαⰡ °¡Àå ÁÁ´Ù. ÀÌ ºê·£µå´Â 320¸¸ ¸íÀÇ ÆäÀ̽ººÏ Ä£±¸°¡ ÀÖ´Â µî Ȱ¹ßÇÏ°Ô È°µ¿Çϰí ÀÖ´Ù. -196ÂÊ
±ä±ÞÇÑ ÀÏÀº Ç×»ó Áß¿äÇÑ ÀϺ¸´Ù ¸ÕÀú ÇÏ°Ô µÈ´Ù. ¿À´Ã³¯ ±â¾÷µéÀÌ °Þ°í ÀÖ´Â ºÐ±âº° ½ÇÀû¿¡ ´ëÇÑ ¾Ð¹ÚÀº ¾öû³ª´Ù. ±×·¡¼ °á±¹ ±â¾÷µéÀÌ ±âÁ¸ Á¦Ç°À» ²ÙÁØÈ÷ °³¼±Çϱâ À§ÇÑ Á¡ÁøÀûÀÎ Çõ½Å¿¡¸¸ Æ÷Ä¿½º¸¦ ¸ÂÃßµµ·Ï ÇÑ´Ù. ÇÙ½ÉÀÇ Çõ½ÅÀ» ÇÏ´Â °ÍÀÌ ½Ç¼ö¶ó´Â ¸»Àº ¾Æ´Ï´Ù. ¿ÀÈ÷·Á ´ëºÎºÐÀÇ ±â¾÷µéÀº ÇÙ½ÉÀÇ Çõ½Å¿¡ ÁýÁßÇÒ Çʿ䰡 ÀÖ´Ù. ÇÏÁö¸¸ ´õ Á¤±³ÇÏ°í ´õ Å« ¾ß¸ÁÀ» À§ÇÑ Çõ½Å ¶ÇÇÑ ÃßÁøµÇ¾î¾ß ÇÒ °ÍÀÌ´Ù. -211ÂÊ

ÁöÀºÀÌ | ·¡¸® ų¸®
Çõ½Å ½ÇÈ¿¼º ºÐ¾ß¿¡¼ ¼¼°èÀûÀ¸·Î ¾Ë·ÁÁø ¼±±¸ÀÚÀÌ´Ù. ±×´Â µðÀÚÀΰú °æ¿µ´ëÇпøÀÇ ±³¼ö·Î¼, ¿¬¼³Àڷμ, ÀÛ°¡·Î¼, ±×¸®°í ¿¬±¸Àڷμ, Çõ½Å½ÇÈ¿¼º°ú ¾¾¸§Çϰí ÀÖ´Ù. ¿Ö Çõ½ÅÀÌ ÁÖ·Î ½ÇÆÐÇÏ´ÂÁö¿¡ ´ëÇÑ ÀÌÇØ¿¡ »ç·ÎÀâÇô, ±×´Â ÀÌ ºÐ¾ß¸¦ ÀÀ¿ëµÈ âÁ¶(applied creativity)ÀÇ ÇÑ ºÐ¾ß¶ó±âº¸´Ù´Â ÇϳªÀÇ Çй®À¸·Î ¼ºÀå½Ã۱â À§ÇØ ³ë·ÂÇϰí ÀÖ´Ù. ±×´Â ±×ÀÇ ¸àÅäÀÎ Á¦ÀÌ µµºí¸°(Jay Doblin)°ú ÇÔ²², 1981³â¿¡ µµºí¸°(Doblin)À» °øµ¿ ⸳ÇÏ¿´°í, 2013³âºÎÅÍ ¸ð´ÏÅÍ µô·ÎÀÌÆ®(Monitor Deloitte)¿¡¼ Ã¥ÀÓÀڷΠȰµ¿Çϰí ÀÖ´Ù. ±×´Â ¸ð´ÏÅÍ µô·ÎÀÌÆ®¿¡¼ ȸ»çÀÇ ±Û·Î¹úÇÑ Çõ½Å ½ÇõÀ» À§ÇÑ À¯´ÉÇÑ ÁöµµÀÚ·Î ÀÏÇϰí ÀÖ´Ù.
·¡¸®´Â 55°³ÀÇ ´Ù¸¥ »ê¾÷ ºÐ¾ß, ¼¼°èÀÇ ¸¹Àº ¼±µÎÀûÀΠȸ»çµé, ±×¸®°í ÀÚ¼± Ȱµ¿ÀÇ Çõ½Å µµÀü¿¡ ´ëÇØ ¿¬±¸ÇÏ¿´´Ù. ±×´Â ½ÃÄ«°í µðÀÚÀÎ ±³À°±â°ü(Chicago¡¯s Institute of Design, ¹Ì±¹¿¡¼ ¹Ú»çÇÐÀ§¸¦ ÁØ ÃÖÃÊÀÇ µðÀÚÀÎ ½ºÄð)ÀÇ ÀÌ»çÀÌÀÚ ¿Ü·¡±³¼öÀÌ´Ù. ÄÌ·Î±× °æ¿µ´ëÇпø(Kellogg Graduate School of Management)ÀÇ °æ¿µÀÚ ±³À° ÇÁ·Î±×·¥¿¡¼ °ÀǸ¦ Çϰí, MBA ÇÁ·Î±×·¥°ú »ý»ê°ü¸® ÇÁ·Î±×·¥(Masters of Manufacturing Management program)À» °¡¸£Ä¡´Â ³ë½º¿þ½ºÅÏ´ëÇÐ °ø°ú´ëÇÐ(Northwestern University¡¯s McCormick School of Engineering)ÀÇ ¿Ü·¡ ±³¼öȸ ȸ¿ø(adjunct faculty member)ÀÌ´Ù. ·¡¸®´Â º¸½ºÅÏ¿¡ ÀÖ´Â ºñÁî´Ï½º Çõ½Å¼¾ÅÍ(Center for Business Innovation)ÀÇ ¼±ÀÓ¿¬±¸¿øÀ̾úÀ¸¸ç, ¸ÞÀÌ¿ä Ŭ¸®´Ð(Mayo Clinic)ÀÇ »ç¿Ü ÀÚ¹®À§¿øÈ¸·Î Ȱµ¿ ÁßÀ̰í, ¶ÇÇÑ µð½º ¾Æ¸Þ¸®Ä ¶óÀÌÇÁ(This American Life)¿Í ´Ù¸¥ Çõ½ÅÀûÀÎ ÇÁ·Î±×·¥À» °³¹ßÇÏ´Â µ¥ ±×°¡ µµ¿òÀ» ÁØ ½ÃÄ«°í °ø¿µ¶óµð¿À(Chicago Public Radio)ÀÇ ÀÌ»çÀÌ´Ù.
ÁöÀºÀÌ | ¶óÀ̾ð ÇÇÄÌ
µµºí¸°ÀÇ µðÀÚÀÎ Àü·«°¡(design strategist)ÀÌ´Ù. ±×´Â °í°´µé°ú, ÃÖÁ¾ÀûÀ¸·Î´Â »ç¿ëÀÚ ¸ðµÎ¿¡°Ô À¯¿ëÇÏ°Ô ¾²ÀÏ ¼ö ÀÖ´Â ¼Ö·ç¼ÇÀ» Ç¥ÇöÇÏ°í °³¹ßÇÒ ¼ö ÀÖµµ·Ï Çõ½Å ÇÁ·Î±×·¥À» ÅëÇØ °í°´µé°ú ÆÀµéÀ» ¾È³»ÇÏ´Â ¿ªÇÒÀ» ÇÑ´Ù. ¶ÇÇÑ, ¶óÀ̾ðÀº µµºí¸°ÀÇ ÀÚü µµ±¸µé°ú °úÁ¤ᅳ10°¡Áö Çõ½Å ÇÁ·¹ÀÓ¿öÅ©, Çõ½Å Àü·«(the Innovation Tactics)°ú °ü·ÃµÈ Àü·« Ä«µå(associated Tactics cards)¸¦ Æ÷ÇÔÇÑᅳÀ» °³¹ßÇÏ´Â µ¥ Áß¿äÇÑ ±â¿©¸¦ ÇÏ¿´´Ù. ¼¿ï°ú ¹³¹ÙÀÌÀÇ °í°´µéÀ» À§ÇØ Çõ½Å ¿ª·® ¼ö¸³À» µ½´Â µ¿¾È, ±×ÀÇ ÀÛ¾÷Àº ¿©·¯ »ê¾÷¿¡ °ÉÃÄÁ® ÀÖ´Ù. ¶óÀ̾ðÀº ±×°¡ Çõ½Å µµ±¸¿Í ±â¼ú¿¡ ´ëÇÑ °ÀǸ¦ ÇÏ´Â IITÀÇ µðÀÚÀα³À°±â°ü(Institute of Design)ÀÇ ¿Ü·¡ ±³¼öȸ ȸ¿øÀ̱⵵ ÇÏ´Ù.
ÁöÀºÀÌ | ºê¶óÀ̾ð Äý
µµºí¸°ÀÇ ¸®´õÀÌ´Ù. ±×´Â °¡Àå Å« °í°´µé Áß ¸î¸îÀÇ ´ë±Ô¸ðÀÇ(scaled) Çõ½Å ÇÁ·Î±×·¥À» ¼³°èÇÏ°í °¨µ¶ÇÑ´Ù. ±×´Â Çõ½ÅÇϱâ À§ÇÏ¿©, ±×¸®°í ´õ È¿°úÀûÀÎ Çõ½ÅÀÚ°¡ µÇ±â À§ÇÏ¿© ±×µé°ú ÀÏÇÑ´Ù. ±×´Â Çõ½Å ¿ª·®À» ½×°í °í°´µéÀ» À§ÇÑ Çõ½ÅÀ» ½ÃÇàÇÏ´Â µ¥ ÇÊ¿äÇÑ È¸»çÀÇ ¸®´õ½ÊÀ» ÁõÁø½ÃŰ´Â µ¥ µµ¿òÀ» ÁØ´Ù. ¶ÇÇÑ ±×´Â 10°¡Áö Çõ½Å ÇÁ·¹ÀÓ¿öÅ©¸¦ °è¼Ó ÁøÈ½ÃŰ´Â ÆÀÀÇ ÁÖ¿ä ¸â¹öÀÌ´Ù. ±×ÀÇ ÀÛ¾÷Àº ¸¹Àº »ê¾÷µé¿¡ °ÉÃÄ Àִµ¥, ƯÈ÷ ±×´Â ÀÇ·á ¼ºñ½º ºÐ¾ß¿¡ °æÇèÀÌ ÀÖ´Ù. ºê¶óÀ̾ðÀº ¶ÇÇÑ ¿µÈ»ê¾÷¿¡¼ ½Ã³ª¸®¿ÀÀÛ°¡·Îµµ Ȱµ¿Çϰí, ¹¦»çÇÏ´Â Èû¿¡ ¸Å·áµÇ¾î ÀÖ´Ù.
ÁöÀºÀÌ | Çï·» ¿ùÅͽº
ÀÛ°¡, ÆíÁýÀÚ, ±×¸®°í µµºí¸°ÀÇ ¿¬±¸ÀÚÀÌ´Ù. ¡°ºñÁî´Ï½ºÀ§Å©¡±ÀÇ(³ªÁß¿¡´Â ¡°ºí·ë¹ö±× ºñÁî´Ï½ºÀ§Å©¡±) Çõ½Å°ú µðÀÚÀÎÀÇ ÆíÁýÀڷΠȰµ¿Çϱâ Àü¿¡, ±×³à´Â, ÀÌ Ã¥¿¡¼ÀÇ ÀÛ¾÷ó·³, ȸ»ç¿¡¼ ÆíÁý Àü·«À» °³¹ß½ÃŰ´Â ¿ªÇÒÀ» ÇÏ¿´´Ù. ¶ÇÇÑ ±×³à´Â 10°¡Áö Çõ½Å ÇÁ·¹ÀÓ¿öÅ©¸¦ °è¼Ó ÀÛ¾÷Çϰí ÀÖ´Â ÆÀ ¸â¹öÀÌ´Ù. ³»ºÎÀûÀ¸·Î´Â ÇູÇÏ°Ô Çõ½Å °úÁ¤À» °üÂûÇÏÁö¸¸, ±×³à´Â ±×³àÀÇ Àú³Î¸®Áò Áßµ¶À» Á¤±âÀûÀ¸·Î ºí·Î±×(Thought You Should See This)¿¡ Àû°í °ÔÀçÇϰí, ¶ÇÇÑ ²÷ÀÓ¾øÀÌ Æ®À§ÆÃ(@helenwalters)À» Çϸç ÀÚ½ÅÀÇ ¿å±¸¸¦ ä¿î´Ù. ±×³à´Â ¶ÇÇÑ TED ÄÁÆÛ·±½ºÀÇ ½Ç½Ã°£ ºí·Î°ÅÀÌ´Ù.
¿Å±äÀÌ | À¯È¿»ó
°æÁ¦ÇÐ ¹Ú»çÀ̸ç, °Ç±¹´ë °æ¿µ´ëÇÐ ±³¼ö¸¦ ¿ªÀÓÇϰí, ÇöÀç´Â ¼÷¸í¿©´ë °æ¿µÀü¹®´ëÇпø(MBA) ±³¼ö·Î ÀçÁ÷ ÁßÀÌ´Ù. »ï¼º±×·ì, µ¿¾ç±×·ì µî ´ë±â¾÷¿¡¼ ±âȹ½ÇÀåÀ¸·Î ±Ù¹«ÇÏ¸ç ½Ç¹° °æÁ¦¿¡ ´ëÇÑ °¨°¢À» ÀÍÇû°í, ÀÏÁø±×·ì â¾÷ ÅõÀÚ»ç ´ëÇ¥¿Í ÄÁ¼³ÆÃ ȸ»ç ´ëÇ¥¸¦ Áö³»¸é¼ ½Å±Ô»ç¾÷, ÇØ¿ÜÅõÀÚ, M&A, º¥Ã³ÅõÀÚ µîÀÇ ¾÷¹«¸¦ ÁøÇàÇß´Ù. ¶ÇÇÑ ¾¾Æ¼ÀºÇà, HSBC µî ¼¼°èÀûÀÎ »ç¸ðÆÝµåÀÇ ±¹³» ÅõÀÚ¸¦ ÀÚ¹®Çß´Ù. µ¿±¹´ë °æ¿µÀü¹®´ëÇпø ±³¼ö·Î ±Ù¹«ÇÏ´ø ´ç½Ã ±¹³» ÃÖÃÊ·Î ¾ÓÆ®·¹ÇÁ·¹³Ê½Ê(Entrepreneurship) MBA °úÁ¤À» °³¼³ÇØ °æÁ¦ °æ¿µ°èÀÇ ÁÖ¸ñÀ» ²ø¾ú´Ù. µ¿±¹´ë ±â¼úÁöÁÖȸ»ç ´ëÇ¥À̻縦 ¿ªÀÓÇÏ¸é¼ ¡®º£½ºÆ® ƼĪ ±³¼ö¡¯(Best Teaching Professor)¿¡µµ ¼±Á¤µÇ´Â µî ½Ç¹°°ú À̷п¡ µÎ·ç Á¤ÅëÇÏ´Ù´Â Æò°¡¸¦ ¹Þ´Â´Ù. ºñÁî´Ï½º ¸ðµ¨ ¿¬±¸¿Í Çõ½Å»ç·Ê ¹× ¼º°øÇÑ ¾ÓÆ®·¹ÇÁ·¹³Ê(Entrepreneur) ¹ß±¼À» ÅëÇÑ ±â¾÷°¡Á¤½Å È®»ê¿¡ ³ë·ÂÇϰí ÀÖ´Ù. Àú¼·Î´Â ¡º½Ã¸ó´À ½ºÅ丮¡», ¡º·Ð½ºÅ¸, ±× ºÒÆíÇÑ Áø½Ç¡», ¿Å±ä Ã¥À¸·Î´Â ¡ººñÁî´Ï½º ¸ðµ¨ÀÇ Åº»ý¡» µîÀÌ ÀÖ´Ù..
Çõ½Å ½ÇÈ¿¼º ºÐ¾ß¿¡¼ ¼¼°èÀûÀ¸·Î ¾Ë·ÁÁø ¼±±¸ÀÚÀÌ´Ù. ±×´Â µðÀÚÀΰú °æ¿µ´ëÇпøÀÇ ±³¼ö·Î¼, ¿¬¼³Àڷμ, ÀÛ°¡·Î¼, ±×¸®°í ¿¬±¸Àڷμ, Çõ½Å½ÇÈ¿¼º°ú ¾¾¸§Çϰí ÀÖ´Ù. ¿Ö Çõ½ÅÀÌ ÁÖ·Î ½ÇÆÐÇÏ´ÂÁö¿¡ ´ëÇÑ ÀÌÇØ¿¡ »ç·ÎÀâÇô, ±×´Â ÀÌ ºÐ¾ß¸¦ ÀÀ¿ëµÈ âÁ¶(applied creativity)ÀÇ ÇÑ ºÐ¾ß¶ó±âº¸´Ù´Â ÇϳªÀÇ Çй®À¸·Î ¼ºÀå½Ã۱â À§ÇØ ³ë·ÂÇϰí ÀÖ´Ù. ±×´Â ±×ÀÇ ¸àÅäÀÎ Á¦ÀÌ µµºí¸°(Jay Doblin)°ú ÇÔ²², 1981³â¿¡ µµºí¸°(Doblin)À» °øµ¿ ⸳ÇÏ¿´°í, 2013³âºÎÅÍ ¸ð´ÏÅÍ µô·ÎÀÌÆ®(Monitor Deloitte)¿¡¼ Ã¥ÀÓÀڷΠȰµ¿Çϰí ÀÖ´Ù. ±×´Â ¸ð´ÏÅÍ µô·ÎÀÌÆ®¿¡¼ ȸ»çÀÇ ±Û·Î¹úÇÑ Çõ½Å ½ÇõÀ» À§ÇÑ À¯´ÉÇÑ ÁöµµÀÚ·Î ÀÏÇϰí ÀÖ´Ù.
·¡¸®´Â 55°³ÀÇ ´Ù¸¥ »ê¾÷ ºÐ¾ß, ¼¼°èÀÇ ¸¹Àº ¼±µÎÀûÀΠȸ»çµé, ±×¸®°í ÀÚ¼± Ȱµ¿ÀÇ Çõ½Å µµÀü¿¡ ´ëÇØ ¿¬±¸ÇÏ¿´´Ù. ±×´Â ½ÃÄ«°í µðÀÚÀÎ ±³À°±â°ü(Chicago¡¯s Institute of Design, ¹Ì±¹¿¡¼ ¹Ú»çÇÐÀ§¸¦ ÁØ ÃÖÃÊÀÇ µðÀÚÀÎ ½ºÄð)ÀÇ ÀÌ»çÀÌÀÚ ¿Ü·¡±³¼öÀÌ´Ù. ÄÌ·Î±× °æ¿µ´ëÇпø(Kellogg Graduate School of Management)ÀÇ °æ¿µÀÚ ±³À° ÇÁ·Î±×·¥¿¡¼ °ÀǸ¦ Çϰí, MBA ÇÁ·Î±×·¥°ú »ý»ê°ü¸® ÇÁ·Î±×·¥(Masters of Manufacturing Management program)À» °¡¸£Ä¡´Â ³ë½º¿þ½ºÅÏ´ëÇÐ °ø°ú´ëÇÐ(Northwestern University¡¯s McCormick School of Engineering)ÀÇ ¿Ü·¡ ±³¼öȸ ȸ¿ø(adjunct faculty member)ÀÌ´Ù. ·¡¸®´Â º¸½ºÅÏ¿¡ ÀÖ´Â ºñÁî´Ï½º Çõ½Å¼¾ÅÍ(Center for Business Innovation)ÀÇ ¼±ÀÓ¿¬±¸¿øÀ̾úÀ¸¸ç, ¸ÞÀÌ¿ä Ŭ¸®´Ð(Mayo Clinic)ÀÇ »ç¿Ü ÀÚ¹®À§¿øÈ¸·Î Ȱµ¿ ÁßÀ̰í, ¶ÇÇÑ µð½º ¾Æ¸Þ¸®Ä ¶óÀÌÇÁ(This American Life)¿Í ´Ù¸¥ Çõ½ÅÀûÀÎ ÇÁ·Î±×·¥À» °³¹ßÇÏ´Â µ¥ ±×°¡ µµ¿òÀ» ÁØ ½ÃÄ«°í °ø¿µ¶óµð¿À(Chicago Public Radio)ÀÇ ÀÌ»çÀÌ´Ù.
ÁöÀºÀÌ | ¶óÀ̾ð ÇÇÄÌ
µµºí¸°ÀÇ µðÀÚÀÎ Àü·«°¡(design strategist)ÀÌ´Ù. ±×´Â °í°´µé°ú, ÃÖÁ¾ÀûÀ¸·Î´Â »ç¿ëÀÚ ¸ðµÎ¿¡°Ô À¯¿ëÇÏ°Ô ¾²ÀÏ ¼ö ÀÖ´Â ¼Ö·ç¼ÇÀ» Ç¥ÇöÇÏ°í °³¹ßÇÒ ¼ö ÀÖµµ·Ï Çõ½Å ÇÁ·Î±×·¥À» ÅëÇØ °í°´µé°ú ÆÀµéÀ» ¾È³»ÇÏ´Â ¿ªÇÒÀ» ÇÑ´Ù. ¶ÇÇÑ, ¶óÀ̾ðÀº µµºí¸°ÀÇ ÀÚü µµ±¸µé°ú °úÁ¤ᅳ10°¡Áö Çõ½Å ÇÁ·¹ÀÓ¿öÅ©, Çõ½Å Àü·«(the Innovation Tactics)°ú °ü·ÃµÈ Àü·« Ä«µå(associated Tactics cards)¸¦ Æ÷ÇÔÇÑᅳÀ» °³¹ßÇÏ´Â µ¥ Áß¿äÇÑ ±â¿©¸¦ ÇÏ¿´´Ù. ¼¿ï°ú ¹³¹ÙÀÌÀÇ °í°´µéÀ» À§ÇØ Çõ½Å ¿ª·® ¼ö¸³À» µ½´Â µ¿¾È, ±×ÀÇ ÀÛ¾÷Àº ¿©·¯ »ê¾÷¿¡ °ÉÃÄÁ® ÀÖ´Ù. ¶óÀ̾ðÀº ±×°¡ Çõ½Å µµ±¸¿Í ±â¼ú¿¡ ´ëÇÑ °ÀǸ¦ ÇÏ´Â IITÀÇ µðÀÚÀα³À°±â°ü(Institute of Design)ÀÇ ¿Ü·¡ ±³¼öȸ ȸ¿øÀ̱⵵ ÇÏ´Ù.
ÁöÀºÀÌ | ºê¶óÀ̾ð Äý
µµºí¸°ÀÇ ¸®´õÀÌ´Ù. ±×´Â °¡Àå Å« °í°´µé Áß ¸î¸îÀÇ ´ë±Ô¸ðÀÇ(scaled) Çõ½Å ÇÁ·Î±×·¥À» ¼³°èÇÏ°í °¨µ¶ÇÑ´Ù. ±×´Â Çõ½ÅÇϱâ À§ÇÏ¿©, ±×¸®°í ´õ È¿°úÀûÀÎ Çõ½ÅÀÚ°¡ µÇ±â À§ÇÏ¿© ±×µé°ú ÀÏÇÑ´Ù. ±×´Â Çõ½Å ¿ª·®À» ½×°í °í°´µéÀ» À§ÇÑ Çõ½ÅÀ» ½ÃÇàÇÏ´Â µ¥ ÇÊ¿äÇÑ È¸»çÀÇ ¸®´õ½ÊÀ» ÁõÁø½ÃŰ´Â µ¥ µµ¿òÀ» ÁØ´Ù. ¶ÇÇÑ ±×´Â 10°¡Áö Çõ½Å ÇÁ·¹ÀÓ¿öÅ©¸¦ °è¼Ó ÁøÈ½ÃŰ´Â ÆÀÀÇ ÁÖ¿ä ¸â¹öÀÌ´Ù. ±×ÀÇ ÀÛ¾÷Àº ¸¹Àº »ê¾÷µé¿¡ °ÉÃÄ Àִµ¥, ƯÈ÷ ±×´Â ÀÇ·á ¼ºñ½º ºÐ¾ß¿¡ °æÇèÀÌ ÀÖ´Ù. ºê¶óÀ̾ðÀº ¶ÇÇÑ ¿µÈ»ê¾÷¿¡¼ ½Ã³ª¸®¿ÀÀÛ°¡·Îµµ Ȱµ¿Çϰí, ¹¦»çÇÏ´Â Èû¿¡ ¸Å·áµÇ¾î ÀÖ´Ù.
ÁöÀºÀÌ | Çï·» ¿ùÅͽº
ÀÛ°¡, ÆíÁýÀÚ, ±×¸®°í µµºí¸°ÀÇ ¿¬±¸ÀÚÀÌ´Ù. ¡°ºñÁî´Ï½ºÀ§Å©¡±ÀÇ(³ªÁß¿¡´Â ¡°ºí·ë¹ö±× ºñÁî´Ï½ºÀ§Å©¡±) Çõ½Å°ú µðÀÚÀÎÀÇ ÆíÁýÀڷΠȰµ¿Çϱâ Àü¿¡, ±×³à´Â, ÀÌ Ã¥¿¡¼ÀÇ ÀÛ¾÷ó·³, ȸ»ç¿¡¼ ÆíÁý Àü·«À» °³¹ß½ÃŰ´Â ¿ªÇÒÀ» ÇÏ¿´´Ù. ¶ÇÇÑ ±×³à´Â 10°¡Áö Çõ½Å ÇÁ·¹ÀÓ¿öÅ©¸¦ °è¼Ó ÀÛ¾÷Çϰí ÀÖ´Â ÆÀ ¸â¹öÀÌ´Ù. ³»ºÎÀûÀ¸·Î´Â ÇູÇÏ°Ô Çõ½Å °úÁ¤À» °üÂûÇÏÁö¸¸, ±×³à´Â ±×³àÀÇ Àú³Î¸®Áò Áßµ¶À» Á¤±âÀûÀ¸·Î ºí·Î±×(Thought You Should See This)¿¡ Àû°í °ÔÀçÇϰí, ¶ÇÇÑ ²÷ÀÓ¾øÀÌ Æ®À§ÆÃ(@helenwalters)À» Çϸç ÀÚ½ÅÀÇ ¿å±¸¸¦ ä¿î´Ù. ±×³à´Â ¶ÇÇÑ TED ÄÁÆÛ·±½ºÀÇ ½Ç½Ã°£ ºí·Î°ÅÀÌ´Ù.
¿Å±äÀÌ | À¯È¿»ó
°æÁ¦ÇÐ ¹Ú»çÀ̸ç, °Ç±¹´ë °æ¿µ´ëÇÐ ±³¼ö¸¦ ¿ªÀÓÇϰí, ÇöÀç´Â ¼÷¸í¿©´ë °æ¿µÀü¹®´ëÇпø(MBA) ±³¼ö·Î ÀçÁ÷ ÁßÀÌ´Ù. »ï¼º±×·ì, µ¿¾ç±×·ì µî ´ë±â¾÷¿¡¼ ±âȹ½ÇÀåÀ¸·Î ±Ù¹«ÇÏ¸ç ½Ç¹° °æÁ¦¿¡ ´ëÇÑ °¨°¢À» ÀÍÇû°í, ÀÏÁø±×·ì â¾÷ ÅõÀÚ»ç ´ëÇ¥¿Í ÄÁ¼³ÆÃ ȸ»ç ´ëÇ¥¸¦ Áö³»¸é¼ ½Å±Ô»ç¾÷, ÇØ¿ÜÅõÀÚ, M&A, º¥Ã³ÅõÀÚ µîÀÇ ¾÷¹«¸¦ ÁøÇàÇß´Ù. ¶ÇÇÑ ¾¾Æ¼ÀºÇà, HSBC µî ¼¼°èÀûÀÎ »ç¸ðÆÝµåÀÇ ±¹³» ÅõÀÚ¸¦ ÀÚ¹®Çß´Ù. µ¿±¹´ë °æ¿µÀü¹®´ëÇпø ±³¼ö·Î ±Ù¹«ÇÏ´ø ´ç½Ã ±¹³» ÃÖÃÊ·Î ¾ÓÆ®·¹ÇÁ·¹³Ê½Ê(Entrepreneurship) MBA °úÁ¤À» °³¼³ÇØ °æÁ¦ °æ¿µ°èÀÇ ÁÖ¸ñÀ» ²ø¾ú´Ù. µ¿±¹´ë ±â¼úÁöÁÖȸ»ç ´ëÇ¥À̻縦 ¿ªÀÓÇÏ¸é¼ ¡®º£½ºÆ® ƼĪ ±³¼ö¡¯(Best Teaching Professor)¿¡µµ ¼±Á¤µÇ´Â µî ½Ç¹°°ú À̷п¡ µÎ·ç Á¤ÅëÇÏ´Ù´Â Æò°¡¸¦ ¹Þ´Â´Ù. ºñÁî´Ï½º ¸ðµ¨ ¿¬±¸¿Í Çõ½Å»ç·Ê ¹× ¼º°øÇÑ ¾ÓÆ®·¹ÇÁ·¹³Ê(Entrepreneur) ¹ß±¼À» ÅëÇÑ ±â¾÷°¡Á¤½Å È®»ê¿¡ ³ë·ÂÇϰí ÀÖ´Ù. Àú¼·Î´Â ¡º½Ã¸ó´À ½ºÅ丮¡», ¡º·Ð½ºÅ¸, ±× ºÒÆíÇÑ Áø½Ç¡», ¿Å±ä Ã¥À¸·Î´Â ¡ººñÁî´Ï½º ¸ðµ¨ÀÇ Åº»ý¡» µîÀÌ ÀÖ´Ù..
![]() |
![]() |